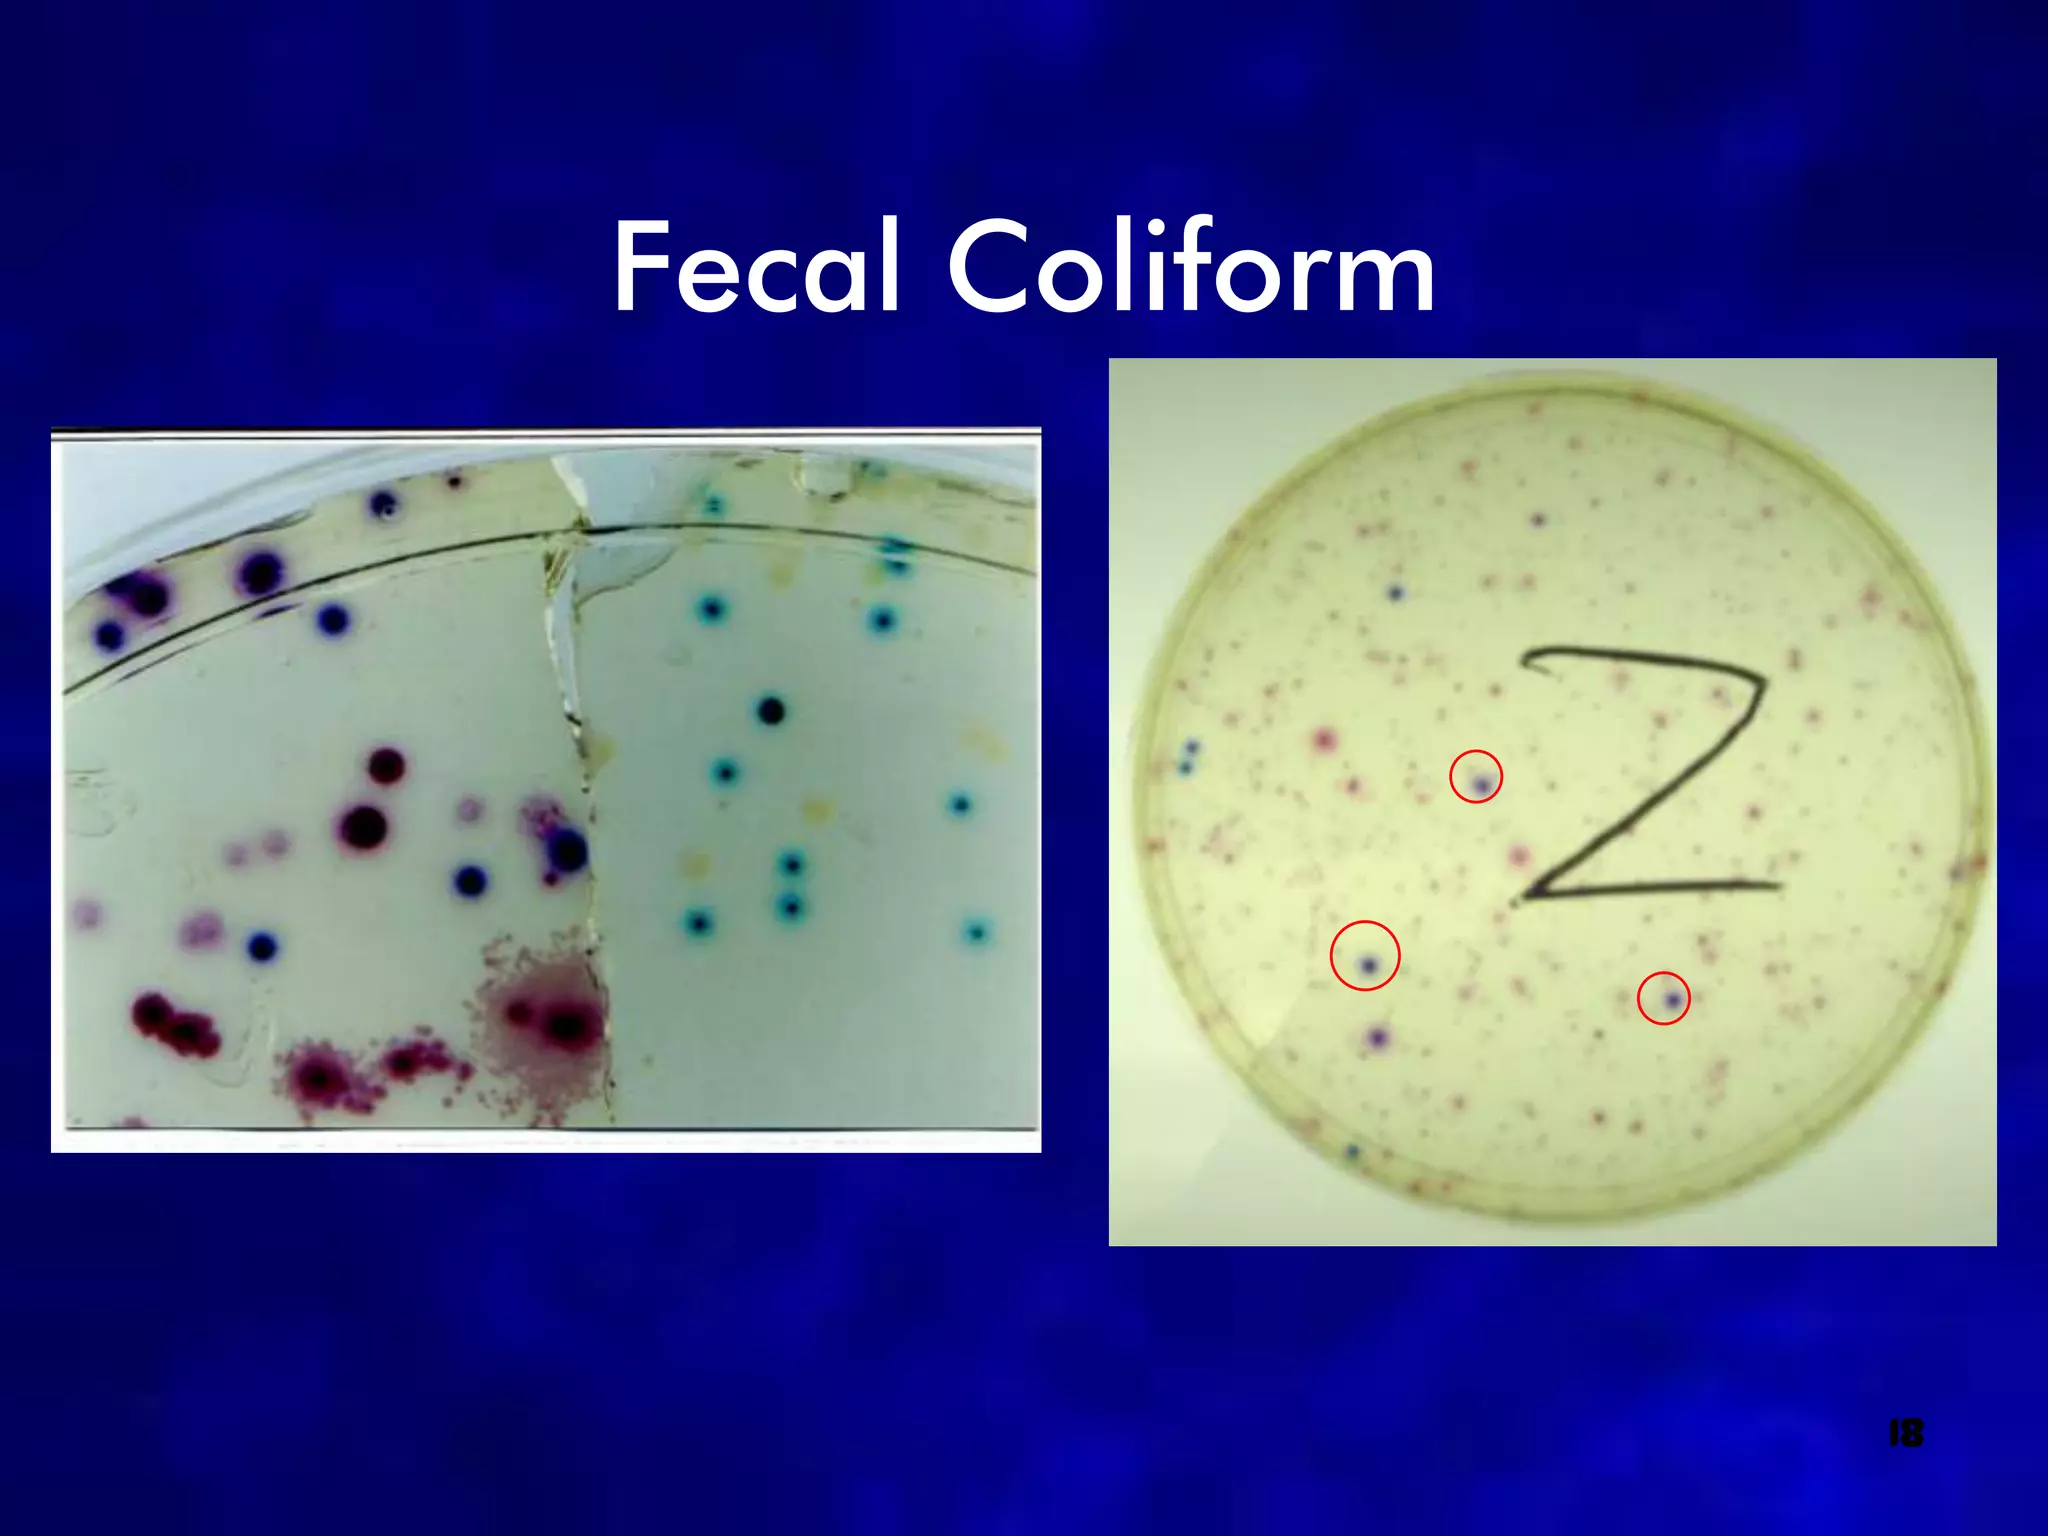
Fecal Coliform




                 18

The document presents the results of a 2008 water quality study of the Shell Creek and Loseke-Taylor Creek watersheds. Water quality tests were conducted at 6 sites along the creeks over 4 sampling periods to analyze parameters like pH, dissolved oxygen, turbidity, E. coli, and biological oxygen demand. The results of these tests were then used to calculate a water quality index for each site to evaluate the overall water quality.